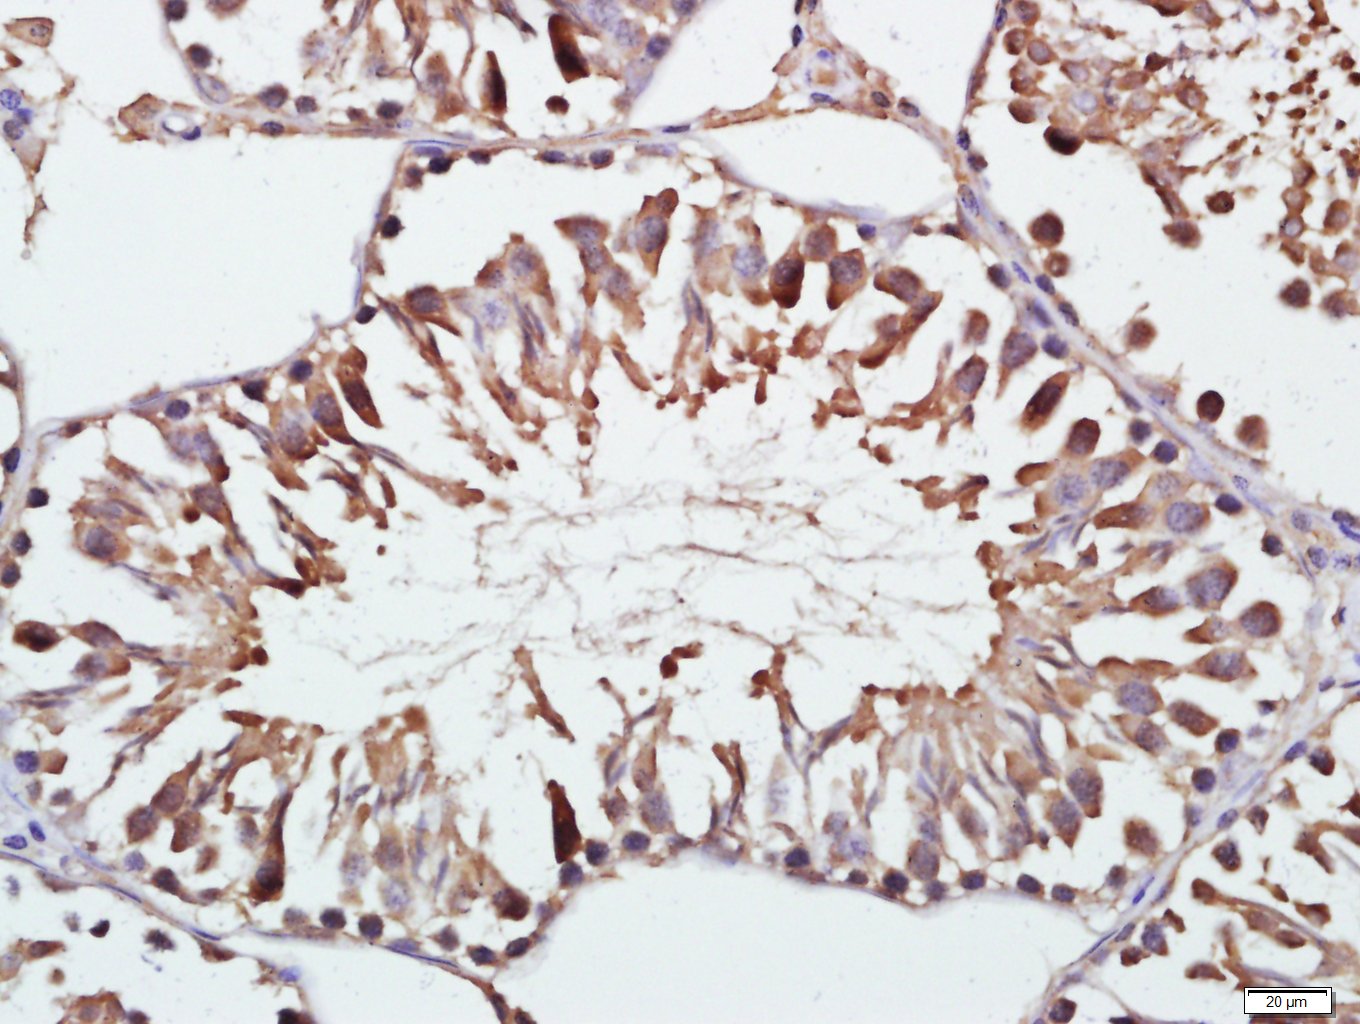
产品细节图片1

相关产品推荐更多 >

RPSA Rabbit pAb, BF594 conjugated(bs-0901R-BF594)-100ul
¥2980
CXorf56 Rabbit pAb, HRP conjugated(bs-9550R-HRP)-100ul
¥2980
ATAT1 Rabbit pAb(bs-9535R)-50ul/100ul/200ul
¥1180
MRPS18B Rabbit pAb(bs-17816R)-50ul/100ul/200ul
¥1180
phospho-HER2 (Tyr1221) Rabbit pAb, APC-Cy7 conjugated(bs-13090R-APC-Cy7)-100ul
¥2980
万千商家帮你免费找货
0 人在求购买到急需产品
- 详细信息
- 文献和实验
- 技术资料
- 应用范围:
产品信息以Bioss网站为准
- 规格:
50ul/100ul/200ul
| 规格: | 50ul | 产品价格: | ¥1180.0 |
|---|---|---|---|
| 规格: | 100ul | 产品价格: | ¥1980.0 |
| 规格: | 200ul | 产品价格: | ¥2800.0 |
| 产品编号 | bs-1160R |
| 英文名称 | Gelsolin Rabbit pAb |
| 中文名称 | 凝溶胶蛋白抗体 |
| 英文别名 | Actin depolymerizing factor; ADF; AGEL; Amyloidosis Finnish type; Brevin; DKFZp313L0718; GSN; GELS_HUMAN; Actin-depolymerizing factor. |
| 产品应用 | IHC-P=1:100-500, IHC-F=1:100-500, IF=1:100-500 Not yet tested in other applications. |
| 交叉反应 | Rat (Human, Mouse) |
| 抗体来源 | Rabbit |
| 免疫原 | KLH conjugated synthetic peptide derived from human Gelsolin |
| 亚型 | IgG |
| 性状 | Liquid |
| 纯化方法 | affinity purified by Protein A |
| 克隆类型 | Polyclonal |
| 理论分子量 | 80 kDa |
| 浓度 | 1mg/ml |
| 储存液 | 0.01M TBS (pH7.4) with 1% BSA, 0.02% Proclin300 and 50% Glycerol. |
| 研究领域 | Signal Transduction > Cytoskeleton / ECM > Cytoskeleton > Microfilaments > Actin etc > Actin Binding Proteins |
| 亚基 | Binds to actin and to fibronectin. Identified in a complex composed of ACTA1, COBL, GSN AND TMSB4X. |
| 亚细胞定位 | Isoform 2: Cytoplasm, cytoskeleton. Isoform 1: Secreted. |
| 组织特异性 | Phagocytic cells, platelets, fibroblasts, nonmuscle cells, smooth and skeletal muscle cells. |
| 翻译后修饰 | Phosphorylation on Tyr-86, Tyr-409, Tyr-465, Tyr-603 and Tyr-651 in vitro is induced in presence of phospholipids. |
| 相似性 | Belongs to the villin/gelsolin family. Contains 6 gelsolin-like repeats. |
| 功能 | Calcium-regulated, actin-modulating protein that binds to the plus (or barbed) ends of actin monomers or filaments, preventing monomer exchange (end-blocking or capping). It can promote the assembly of monomers into filaments (nucleation) as well as sever filaments already formed. Plays a role in ciliogenesis. |
| 保存条件 | Shipped at 4℃. Store at -20℃ for one year. Avoid repeated freeze/thaw cycles. |
| 注意事项 | This product as supplied is intended for research use only, not for use in human, therapeutic or diagnostic applications. |
| 背景资料 | bs-1160P is one synthetic peptide derived from human Gelsolin. Gelsolin is a calcium dependent actin binding protein. It is a potent modulator of actin filament length and gelation. Gelsolin has been shown to exist in at least two variant forms, cytoplasmic gelsolin and plasma gelsolin. Plasma gelsolin has also been called actin depolymerizing factor (ADF) or brevin. Human plasma and rabbit macrophage gelsolins differ by the presence of a 25 amino acid residue extension at the NH2 terminus in the human plasma gelsolin, which appears to account for the difference in relative molecular weights. |
| 应用 | 推荐稀释比例 |
| {IHC-P} | {1:100-500} |
| {IHC-F} | {1:100-500} |
| {IF} | {1:100-500} |

风险提示:丁香通仅作为第三方平台,为商家信息发布提供平台空间。用户咨询产品时请注意保护个人信息及财产安全,合理判断,谨慎选购商品,商家和用户对交易行为负责。对于医疗器械类产品,请先查证核实企业经营资质和医疗器械产品注册证情况。
 文献和实验
文献和实验= NAL), appears to form upon oxidative cyclization of the nonfluorescent 2:1 lysine-HNE Michael adduct-Schiff base cross-link (Scheme 1). Polyclonal antibody (PAb) to the NAL-HNE fluorophore was raised in rabbit and found to be highly specific
Functional Characterization of Proteins Regulating Actin Assembly
Protocol 7: Measurements of the Treadmilling of Actin Filaments Support Protocol 1: Actin Purification from Rabbit Muscle Support Protocol 2: Preparation of Pyrenyl‐Labeled Actin Support
/96T 2000/3000 进口分装 F0021 骨成型蛋白-9(BMP-9) ELISA 48T/96T 2000/3000 进口分装 F0022 BMP-R1A ELISA 48T/96T 2000/3000 进口分装 F0023 BMP-R2 ELISA 48T/96T 2000/3000 进口分装 F0024 BTC ELISA 48T/96T 2000/3100 进口分装 F0030 CAE-Ab ELISA 96
 技术资料
技术资料暂无技术资料 索取技术资料






